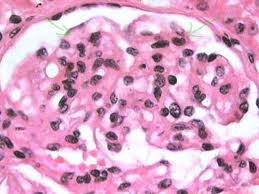
Síndrome nefrótico en niños.jpeg

Síndrome nefrótico en niños
| ||||
Síndrome nefrótico en niños. Es causado por diversos trastornos que producen daño renal. Este daño ocasiona la liberación de demasiada proteína en la orina. Está presente desde el nacimiento o aparece durante los tres primeros meses de vida.
Este trastorno es muy precoz, grave y resistente a los tratamientos. Las complicaciones infecciosas y nutricionales son frecuentes. La función renal se deteriora, lo que justifica la instauración de un programa de diálisis o trasplante de riñón entre los 5 y 8 años.
La enfermedad no recidiva después del trasplante renal. La esclerosis mesangial difusa es la segunda causa de síndrome nefrótico congénito e infantil y puede ser aislada o formar parte del síndrome de Denys-Drash (nefropatía asociada a seudohermafroditismo masculino y a nefroblastoma).
El síndrome nefrótico no responde a los tratamientos. La insuficiencia renal aparece durante la primera infancia. En el 80% de los casos de síndrome de Denys-Drash, existen mutaciones del gen WT1. El objetivo del tratamiento es prevenir la aparición de las complicaciones: edemas, desnutrición, infección y trombosis.
Sumario
Causas
- Cáncer
- Enfermedades como la diabetes, Lupus Eritematoso Sistémico, mieloma múltiple y amiloidosis.
- Trastornos genéticos
- Trastornos inmunitarios
- Infecciones tales como amigdalitis, hepatitis o mononucleosis.
- Uso de ciertas drogas
También puede ocurrir con trastornos renales, como:
- Glomeruloesclerosis segmentaria y focal
- Glomerulonefritis.
- Glomerulonefritis mesangiocapilar
El síndrome nefrótico puede afectar a todos los grupos de edades y, en los niños, es más común entre edades de 2 a 6 años. Este trastorno se presenta con una frecuencia ligeramente mayor en los hombres que en las mujeres.
Síntomas
La hinchazón (edema) es el síntoma más común y puede ocurrir:
- En la cara y alrededor de los ojos (hinchazón facial)
- En los brazos y las piernas, especialmente en los pies y los tobillos
- En el área abdominal (abdomen inflamado)
- Apariencia espumosa en la orina
- Inapetencia
- Aumento de peso (involuntario) por retención de líquidos
Signos clínicos
Las principales manifestaciones del síndrome nefrótico son:
- Una proteinuria superior a 3,5 g /24 h /1,73 m² s y 40 mg/h/m2 en niños (entre 3 y 3,5 g/24 h se considera proteinuria en rango nefrótico). En ausencia de un examen de orina de 24 horas para medir la proteína total se suele usar la relación entre la concentración urinaria de albúmina y creatinina. En el síndrome nefrótico este cociente es superior a 200-400 mg/mmol. Esta gran pérdida de proteínas se debe a un aumento de la permeabilidad del glomérulo, que deja pasar las proteínas a la orina en vez de retenerlas en la sangre. En condiciones normales no se pierden más de 1,5 g/24 h.
- Una hipoalbuminemia inferior a 2,5 g/dL, que sobrepasa la compensación hepática, es decir, la síntesis proteica en el hígado resulta insuficiente para compensar el bajo nivel de proteínas en la sangre.
- El edema, ocasionado por la hipoalbuminemia y la retención de sodio y agua, estimulada esta contención por la hormona antidiurética. Este edema del síndrome nefrótico aparece, inicialmente, en zonas declives (tales como las piernas) y en los párpados; en fases avanzadas se extiende también a cavidades pleurales y peritoneales (ascitis) hasta la anasarca.
- La hiperlipidemia es consecuencia del aumento de la síntesis de lipoproteínas de baja y muy baja densidad responsable del transporte de colesterol y triglicéridos; además, hay un incremento de la síntesis hepática de colesterol.
- La hipercoagulabilidad, entendida como una mayor predisposición a la formación de trombos sanguíneos, es debida a la disminución en la sangre de la antitrombina III por su pérdida urinaria.
- La liupiduria o pérdida de lípidos por la orina es indicativo de patología glomerular debida al incremento de filtración de las lipoproteínas.
Pruebas y exámenes
El médico llevará a cabo un examen físico. Asimismo, se harán pruebas de laboratorio para ver qué tan bien están funcionado los riñones. Entre ellas están:
- Examen de albúmina en la sangre
- Exámenes de química sanguínea tales como grupo de pruebas metabólicas básicas y el grupo de pruebas metabólicas completas
- Nitrógeno ureico en sangre (BUN)
- Examen de creatinina en sangre.
- Depuración de creatinina, examen de orina.
- Análisis de orina
Con frecuencia, también hay presencia de grasas en la orina. Los niveles de colesterol y triglicéridos en la sangre se pueden incrementar. Se puede necesitar una biopsia del riñón para encontrar la causa del trastorno.
Otras pruebas
- Anticuerpo antinuclear
- Crioglobulinas
- Niveles del complemento
- Examen de tolerancia a la glucosa
- Anticuerpos para hepatitis B y C
- Prueba de VIH
- Factor reumatoideo
- Electroforesis de proteínas séricas (EPS)
- Serología para sífilis
- Electroforesis de proteínas urinarias (EPU)
Esta enfermedad también puede alterar los resultados de los siguientes exámenes:
- Nivel de vitamina D
- Hierro sérico
- Cilindros urinarios
Tratamiento
Los objetivos del tratamiento son aliviar los síntomas, prevenir las complicaciones y retrasar el daño renal. Para controlar el síndrome nefrótico usted debe tratar el trastorno causante. El tratamiento se puede requerir de por vida.
- Mantenga la presión arterial en o por debajo de 130/80 mmHg para demorar el daño renal. Los inhibidores de la enzima convertidora de angiotensina (IECA) y los bloqueadores de los receptores de angiotensina (BRA) son los medicamentos que se emplean con mayor frecuencia en este caso. Los inhibidores ECA también pueden ayudar a disminuir la cantidad de pérdida de proteína en la orina.
- Puede tomar corticosteroides o cualquier otro fármaco que inhiba o calme el sistema inmunitario.
- Trate los niveles altos de colesterol para reducir el riesgo de problemas vasculares y cardíacos. Una dieta baja en grasas y en colesterol por lo general no es tan útil para las personas con síndrome nefrótico. Es posible que necesite medicamentos para reducir el colesterol y los triglicéridos (por lo regular las estatinas).
- Una dieta baja en sal puede ayudar con la hinchazón en las manos y las piernas. Los diuréticos también pueden aliviar este problema.
- Las dietas bajas en proteínas pueden servir. Su médico puede recomendar una dieta moderada en proteínas (1 gramo de proteína diario por kilogramo de peso corporal).
- Puede necesitar suplementos de vitamina D si el síndrome nefrótico es crónico y no responde a la terapia.
- Se pueden requerir anticoagulantes para tratar o prevenir la formación de coágulos.
Pronóstico
El desenlace clínico varía. El trastorno puede ser agudo y a corto plazo, o crónico y sin respuesta al tratamiento. Las complicaciones que se presentan pueden también afectar el resultado. Algunas personas pueden finalmente necesitar diálisis y un trasplante de riñón.
Posibles complicaciones
- Insuficiencia renal aguda
- Ateroesclerosis y cardiopatías conexas
- Enfermedad renal crónica
- Hipervolemia, Insuficiencia Cardíaca Congestiva en recién nacidos, Edema pulmonar
- Infecciones, incluyendo neumonía neumocócica
- Desnutrición
- Trombosis de la vena renal
Consulte con su médico si:
- Presenta síntomas del síndrome nefrótico.
- El síndrome nefrótico no desaparece.
- Presenta nuevos síntomas como:
- Tos
- Disminución del gasto urinario
- Molestia al orinar
- Fiebre
- Dolor de cabeza fuerte
- Úlceras en la piel
Prevención
El tratamiento de afecciones que puedan causar el síndrome nefrótico puede ayudar a prevenirlo.